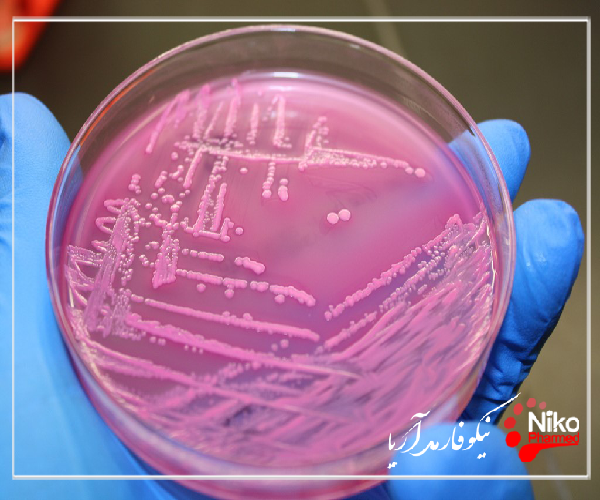
M/تست  سمیت گوارشی

تست سمیت گوارشی؛ سمیت گوارشی داروهای ضدالتهابی غیر استروئیدی غیرانتخابی (NSAIDs) به معده و دوازدهه اول محدود نمی شود، بلکه در پایین دست در سطح روده کوچک، روده بزرگ و راست روده نیز اعمال می شود. مصرف طولانی مدت NSAID در اکثر بیماران باعث ایجاد انتروپاتی تحت بالینی می شود که با افزایش نفوذپذیری روده و التهاب مشخص می شود. این آنتروپاتی می تواند منجر به خونریزی مزمن تقطیر و از دست دادن پروتئین منجر به کم خونی فقر آهن و هیپوآلبومینمی شود. NSAID ها همچنین باعث ایجاد ضایعات زخمی در روده کوچک می شوند. عوارض حاد این زخم ها، خونریزی یا سوراخ شدن، نادر است، همانطور که تنگی دیافراگم ناشی از اسکار است. در کولون و رکتوم، NSAID ها می توانند ضایعات جدید، از جمله کولیت غیراختصاصی و پروکتیت و همچنین زخم هایی را که ممکن است تا تشکیل دیافراگم پیشرفت کنند، ایجاد کنند.

برای کسب اطلاعات بیشتر و دریافت خدمات با ما تماس بگیرید.
نقش آنها در بروز کولیت ایسکمیک سگمنتال نیز دخیل بوده است. در بیماران مبتلا به دیورتیکولوز، خطر عوارض سپتیک شدید و سوراخ شدن را افزایش می دهند. در نهایت، آنها می توانند باعث شعله ور شدن کولیت اولسراتیو یا بیماری کرون شوند. مهارکننده های انتخابی COX-2 نسبت به مهارکننده های غیرانتخابی کمتر انتروتوکسیک هستند اما به طور کامل در برابر عوارض روده ای محافظت نمی کنند. مطالعات تجربی احتمال سمیت را در روده کوچک قبلا سالم در طول درمان طولانی مدت نشان می دهد. علاوه بر این، به نظر میرسد این مولکولهای جدید، مانند مهارکنندههای غیرانتخابی، میتوانند باعث تشدید بیماری التهابی روده شوند.
انجام تست سمیت گوارشی
سمیت گوارشی داروهای ضدالتهابی غیراستروئیدی معمولی (NSAIDs) به معده و دوازدهه پروگزیمال محدود نمی شود، بلکه به بقیه روده کوچک، روده بزرگ و راست روده نیز گسترش می یابد. درمان طولانی مدت NSAID معمولاً باعث ایجاد آنتروپاتی خاموش بالینی می شود که با التهاب و افزایش نفوذپذیری دیواره روده مشخص می شود. حداقل خونریزی مزمن و از دست دادن پروتئین ممکن است منجر به کم خونی فقر آهن و هیپوآلبومینمی شود. NSAID ها همچنین می توانند باعث ایجاد زخم روده کوچک شوند که به ندرت منجر به خونریزی حاد، سوراخ شدن یا اسکار مزمن می شود که باعث تنگی های دیافراگمی می شود. در کولون و رکتوم، استفاده از NSAID می تواند منجر به ضایعات جدید مانند کولیت و رکتیت غیراختصاصی، زخم، و تنگی دیافراگم شود. NSAID ها در ایجاد کولیت ایسکمیک سگمنتال نقش دارند. در بیماران مبتلا به بیماری دیورتیکولی، استفاده از NSAID خطر عفونت شدید دیورتیکول و سوراخ شدن آن را افزایش می دهد. NSAID ها می توانند باعث تشدید کولیت اولسراتیو یا بیماری کرون شوند. با مهارکننده های انتخابی COX-2، خطر مسمومیت گوارشی در مقایسه با NSAID های معمولی کاهش می یابد، اما به طور کامل حذف نمی شود. مطالعات تجربی نشان می دهد که درمان طولانی مدت با مهارکننده COX-2 ممکن است باعث آسیب به روده کوچک قبلا سالم شود. مشابه NSAID های معمولی، مهارکننده های COX-2 ممکن است قادر به تشدید بیماری التهابی روده باشند.
عوارض روده ای داروهای ضدالتهاب غیراستروئیدی غیرانتخابی (NSAIDs) که کمتر از عوارض گوارشی دوازدهه شایع است، مدت هاست که درک نشده و دست کم گرفته شده اند. اکنون به خوبی ثابت شده است که سمیت گوارشی این داروها به معده و دوازدهه اول محدود نمی شود، بلکه در پایین دست، روی کل روده کوچک، روده بزرگ و راست روده نیز اعمال می شود.
ضایعات ناشی از NSAID ممکن است در مخاط سالم روده ایجاد شود یا ممکن است بیماری روده از قبل موجود را پیچیده کند. هنگامی که این وضعیت ناشناخته بود، درمان NSAID می تواند آن را آشکار کند. عوارض روده ای بالقوه متعدد است و برخی می توانند تهدید کننده زندگی باشند (جدول 1). بنابراین این آسیب شناسی ناخوشایند باید برای تجویز کنندگان کاملاً شناخته شده باشد. توسعه مهارکننده های انتخابی COX-2 که در حال حاضر توسط کوکسیب ها ارائه می شود، همه مشکلات را حل نکرده است. سمیت روده ای آنها هنوز به خوبی درک نشده است. هدف از این بررسی، توصیف عوارض روده ای ناشی از NSAID ها و همچنین روش های مدیریت آنها و بررسی دانش در مورد میزان سمیت روده ای مولکول های جدید است.
مقالات بیشتر:
مراحل اصلی بیماری زایی سمیت NSAID ها بر روی روده کوچک در شکل شماتیکی می باشد.
اول، NSAID ها نفوذپذیری مخاط روده را افزایش می دهند. طبق فرضیه ارائه شده توسط گروه Bjarnason، این اثر عمدتاً مبتنی بر مسدود کردن فسفوریلاسیون اکسیداتیو در انتروسیت ها تحت تأثیر غلظت بالای NSAID ها در داخل مجرا پس از مصرف خوراکی آنها و در طی چرخه های کبدی مکرر است. که در
همهگیرشناسی
اطلاعات اپیدمیولوژیک در مورد فراوانی عوارض روده ای مرتبط با NSAID کمیاب است. اولین منبع اطلاعات پایگاه داده ARAMIS آمریکای شمالی است که به مدت سی سال امکان جمع آوری آینده نگر داده های بالینی و درمانی را در گروهی از بیماران روماتولوژیک فراهم کرده است. از این پایگاه داده، بروز سالانه بستری شدن در بیمارستان برای عوارض گوارشی تحتانی مرتبط با NSAID ها بود.
اثرات نامطلوب NSAID ها بر روده کوچک
مهم است که آسیب روده تحت بالینی را تشخیص دهیم - اختلالات نفوذپذیری، التهاب روده - که اکثر بیمارانی را تحت تاثیر قرار می دهد که درازمدت NSAID ها و عوارض بالینی، گاهی جدی - خونریزی، سوراخ شدن - که فقط در تعداد کمی از بیماران رخ می دهد.
سمیت کولورکتال NSAID ها
NSAID ها می توانند ضایعات جدید کولورکتال را ایجاد کنند، به عنوان مثال در یک کولون قبلاً سالم رخ می دهد. آنها همچنین می توانند پیشرفت یک بیماری از قبل موجود مانند دیورتیکولوز یا بیماری التهابی مزمن روده را پیچیده کنند.
سمیت کولون NSAID ها توسط فرم های گالنیک با رهش طولانی مدت که غلظت های محلی بالاتری از NSAID ها را در تماس مستقیم با مخاط کولون پروگزیمال فراهم می کند، مورد توجه قرار می گیرد. سمیت موضعی
سمیت روده ای مهارکننده های انتخابی COX-2
طرح ساده ای که به COX-1 سنتز PG های فیزیولوژیکی و COX-2 سنتز PG های پاتولوژیک را نسبت می دهد با واقعیت بیولوژیکی مطابقت ندارد. اکنون به خوبی ثابت شده است که مهار هر یک از این ایزوآنزیم ها بسته به زمینه، پیامدهای مفید یا مضری دارد.
فرآیند مجوز افزودنی های غذایی در جهان
تنها هدف در فرآیند مجوز افزودنی های غذایی، حفاظت از سلامت انسان در استفاده است. افزودنی های غذایی گروه بسیار خاصی از مواد شیمیایی هستند که افراد با آن مواجه می شوند. افراد می توانند بر خلاف میل خود از بدو تولد تا مرگ در معرض این مواد قرار گیرند. با توجه به اینکه صدها میلیون نفر از مواد غذایی حاوی مواد افزودنی استفاده می کنند، واضح است که کوچکترین اشتباهی مشکل بزرگی برای سلامت انسان ایجاد خواهد کرد. به دلیل این ویژگی، مجوز استفاده از افزودنی های غذایی در نتیجه بررسی شدید و دقیق مقامات بهداشتی بین المللی و ملی داده می شود. در این فرآیند، با استفاده از فرصتهای علم و فناوری امروزی، تحقیقات فشرده انجام میشود. از این حیث، استفاده از افزودنی های غذایی از گروه مواد شیمیایی است که از نظر حفظ سلامت انسان تحت شدیدترین کنترل قرار می گیرد.
همانطور که قبلا گفته شد، هر ماده شیمیایی به روشی وابسته به دوز سمی است. اولین گام در فرآیند اجازه استفاده از افزودنی های غذایی این است که تعیین کنیم این ماده شیمیایی در چه دوز (مقادیر) چه اثراتی را در حیوانات آزمایشی نشان می دهد یا نخواهد کرد. به عبارت دیگر، تعیین «حدود بی ضرری» است. آسیب ناشی از مواد شیمیایی موجود در بدن را سمیت می گویند. سمیت یک روش عمل همه کاره است. تمام اثرات سمی احتمالی با تجویز ماده شیمیایی مورد آزمایش در دوزهای مختلف، از جمله دوزهای بالا، بر روی حیوانات آزمایشی بررسی میشود (معمولاً از جوندگانی مانند موش، موش صحرایی و خوکچه هندی برای این منظور استفاده میشود). واحد دوز مصرفی mg/kg است. به عبارت دیگر، این ماده آزمایشی است که بر حسب میلی گرم به ازای هر کیلوگرم وزن زنده حیوان آزمایشی داده می شود. دلیل اینکه جوندگان عمدتاً در آزمایش های سمیت استفاده می شوند این است که این حیوانات در گروه پستانداران قرار دارند، آناتومی و فیزیولوژی به خوبی شناخته شده است، شرایط آزمایش در طول آزمایش قابل کنترل است و می توان از تعداد کافی حیوانات برای رسیدن به نتایج آماری استفاده کرد. در شرایط خاص، سایر پستانداران مانند گربه، سگ، پستانداران نیز می توانند در تست سمیت استفاده شوند. در آزمایشات سمیت، به طور متوسط 100 حیوان آزمایشی وجود دارد که حداقل 10 حیوان در هر گروه دوز و گروه کنترل وجود دارد. در آزمایش های سمیت، تقریباً 3000 حیوان آزمایشی برای یک ماده شیمیایی استفاده می شود. این آزمایش ها در آزمایشگاه هایی که مطابق با قوانین تعیین شده توسط سازمان های بین المللی کار می کنند انجام می شود. مطالعات سمیت زیر در حیوانات آزمایشگاهی برای افزودنی های غذایی و همچنین برای تمام مواد شیمیایی مورد استفاده به ویژه داروها انجام می شود.
الف. مطالعات سموم سینتیکی: جذب (انتقال به خون)، توزیع (انتقال به اندامها با کمک خون) افزودنی مورد بررسی در ارگانیسم. تبدیل زیستی (تبدیل به سایر مواد شیمیایی در بدن) و دفع آن مورد مطالعه قرار می گیرد.
ب. تست های سمیت: آزمایش های سمیت عمده در زیر نشان داده شده است.
سمیت حاد: مسمومیت ناشی از مصرف بیش از یک دوز در یک یا 24 ساعت.
مسمومیت مزمن: مسمومیت ناشی از مصرف طولانی مدت دوزهای کم که باعث مسمومیت حاد نمی شود.
اثر جهش زا: تغییر دائمی در DNA.
اثر سرطان زا: اثر سرطان زا.
اثر تراتوژنیک: اثری که منجر به تولد فرزندان فلج می شود.
اثر سرطان زای ترانس جفت: ایجاد سرطان سالها پس از تولد در کودک باردار.
اثر ایمونوتوکسیک: اثر سمی بر سیستم ایمنی بدن.
اثر سمی بر سیستم تولید مثل
اثر نوروتوکسیک: اثر سمی بر روی سیستم عصبی.
تست های سمیت فوق برای آلاینده های مواد غذایی نیز اعمال می شود. از آنجایی که نمی توان از آلودگی مواد غذایی توسط آلاینده های شیمیایی که به آنها آلاینده می گویند جلوگیری کرد، باید مقادیری را مشخص کرد که در صورت مصرف مادام العمر این آلاینده ها به سلامت انسان آسیبی وارد نکند. از آنجایی که مواد افزودنی و آلایندههای غذایی در طول زندگی مصرف میشوند، این پدیده در آزمایشهایی که با حیوانات آزمایشی انجام میشود در تعیین مدت زمان آزمایش مورد توجه قرار میگیرد. آزمایشهای سمیت مزمن و سرطانزایی با تجویز ماده شیمیایی مورد آزمایش بر روی حیوان آزمایشی هر روز برای یک دوره زمانی (18-16 ماه) انجام میشود که 70 تا 80 درصد از میانگین طول عمر حیوانات آزمایشی را پوشش میدهد.
مقالات بیشتر:
تست خون سازگاری و هولیز کنندگی
تشخیص اشرشیا کلی در محصولات پزشکی
نتایج تست سمیت توسط کمیته های علمی تشکیل شده توسط سازمان های بین المللی/ملی برای رسیدن به مقادیر عددی مورد نیاز برای استفاده ایمن ارزیابی می شود. در دستیابی به این مقادیر، اگر ماده شیمیایی مورد بررسی سالها مورد استفاده قرار گرفته باشد، از نتایج مطالعات اپیدمیولوژیک بهدستآمده از گروههای انسانی نیز استفاده میشود. به عنوان مثال، ساخارین بیش از 100 سال است که به عنوان یک شیرین کننده مصنوعی استفاده می شود. از آنجایی که یک قرن پیش هیچ قانون بینالمللی و آزمایش سمیتی که امروزه برای ایمنی افزودنیهای غذایی اعمال میکنیم وجود نداشت، ساخارین بدون گذراندن آزمایشهای فوق شروع به استفاده کرد. آزمایش های فوق برای ساخارین پس از دهه 1960 انجام شد. امروزه هنگام ارزیابی ایمنی ساخارین، هم از نتایج آزمایشهای سمیت در حیوانات آزمایشگاهی و هم از دادههای اپیدمیولوژیک بهدستآمده از گروههای انسانی که سالها از آن استفاده میکنند، استفاده میشود. در مورد ماده جدیدی که به عنوان یک افزودنی غذایی ساخته شده است، تنها داده ای که در اختیار داریم نتایج آزمایش سمیت است. بر اساس این مقادیر مشخص می شود که چه مقدار از افزودنی های غذایی را می توان در کدام غذا استفاده کرد.





